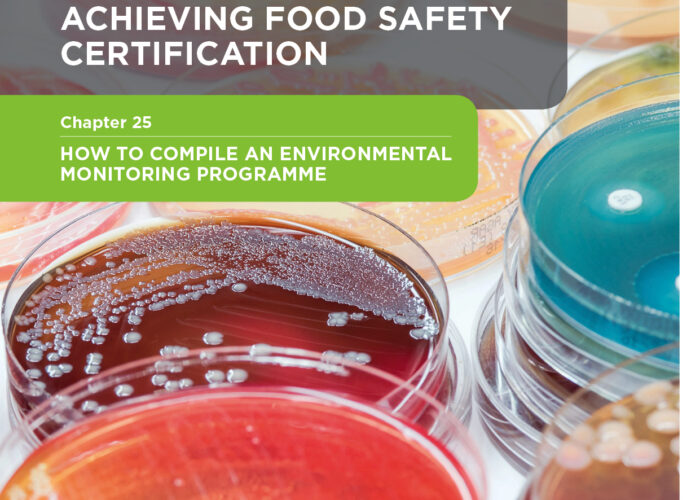
2.25. Your guide to establishing an Environmental Monitoring Plan – Chapter 25

2.27. How to implement a Food Safety Culture
by Entecom /
eBooks /
2022-05-04
When it comes to food safety, there can be no shortcuts, it’s
Continue Reading